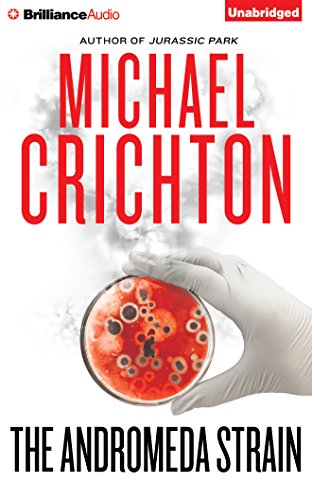

All Departments
The Andromeda Strain
Best Price on Amazon
$USD 8.99
Buy on Amazon »
Last Update: 2019-09-20 14:17:26